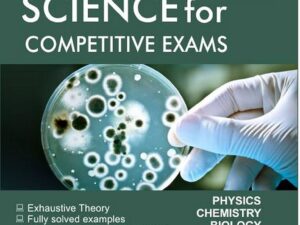
General Science

Competitive books
- Sale!

SSC General Awareness S/P
₹725.00Original price was: ₹725.00.₹580.00Current price is: ₹580.00.Add to cart - Sale!

SSC Reasnoning
₹735.00Original price was: ₹735.00.₹543.00Current price is: ₹543.00.Add to cart - Sale!

SSC English Language Solved Papers
₹735.00Original price was: ₹735.00.₹580.00Current price is: ₹580.00.Add to cart - Sale!

Test of Reasoning
₹445.00Original price was: ₹445.00.₹334.00Current price is: ₹334.00.Add to cart - Sale!

Test of Arithmetic
₹535.00Original price was: ₹535.00.₹401.00Current price is: ₹401.00.Add to cart - Sale!

151 Essays
₹395.00Original price was: ₹395.00.₹290.00Current price is: ₹290.00.Add to cart - Sale!

General Knowledge
₹65.00Original price was: ₹65.00.₹50.00Current price is: ₹50.00.Add to cart - Sale!

Indian Polity by M. Laxmikanth English Medium 8th Edition
₹1,090.00Original price was: ₹1,090.00.₹720.00Current price is: ₹720.00.Select options This product has multiple variants. The options may be chosen on the product page - Sale!

భారత రాజకీయ వ్యవస్థ
₹925.00Original price was: ₹925.00.₹694.00Current price is: ₹694.00.Add to cart - Sale!

Objective Indian Polity
₹525.00Original price was: ₹525.00.₹420.00Current price is: ₹420.00.Add to cart - Sale!

Bharatha Rajyangam, Rajakiya vyavastha & Paripalana
₹850.00Original price was: ₹850.00.₹719.00Current price is: ₹719.00.Add to cart - Sale!

Introduction to The Constitution of India
₹675.00Original price was: ₹675.00.₹550.00Current price is: ₹550.00.Add to cart - Sale!

Indian Physical Geography
₹399.00Original price was: ₹399.00.₹327.00Current price is: ₹327.00.Select options This product has multiple variants. The options may be chosen on the product page - Sale!

Geographical Insights
₹795.00Original price was: ₹795.00.₹636.00Current price is: ₹636.00.Add to cart - Sale!

Physical Geography
₹499.00Original price was: ₹499.00.₹395.00Current price is: ₹395.00.Select options This product has multiple variants. The options may be chosen on the product page - Sale!

Citizens & Constitution of India | Subhash C. Kashyap – Guide to Rights, Duties and Governance
₹210.00Original price was: ₹210.00.₹189.00Current price is: ₹189.00.Add to cart - Sale!

Courseware on Indian Economy
₹725.00Original price was: ₹725.00.₹580.00Current price is: ₹580.00.Add to cart - Sale!

Environment
₹599.00Original price was: ₹599.00.₹539.00Current price is: ₹539.00.Add to cart - Sale!

Science & Technology by Ravi Agrahari (9th Edition)
₹995.00Original price was: ₹995.00.₹697.00Current price is: ₹697.00.Add to cart - Sale!

Environment
₹750.00Original price was: ₹750.00.₹640.00Current price is: ₹640.00.Add to cart - Sale!

Blackbook of General Awareness
₹520.00Original price was: ₹520.00.₹468.00Current price is: ₹468.00.Add to cart - Sale!

A Brief History of Modern India
₹635.00Original price was: ₹635.00.₹410.00Current price is: ₹410.00.Add to cart - Sale!

Rapedix English speaking course
₹350.00Original price was: ₹350.00.₹278.00Current price is: ₹278.00.Add to cart - Sale!

Adhunika Bharathadesha Charithra (T/M)
₹400.00Original price was: ₹400.00.₹350.00Current price is: ₹350.00.Add to cart - Sale!

Madhyayugala Bharathadesham (T/M)
₹450.00Original price was: ₹450.00.₹360.00Current price is: ₹360.00.Add to cart - Sale!

Swathanthram tharuvatha Bharathadesham
₹650.00Original price was: ₹650.00.₹550.00Current price is: ₹550.00.Add to cart - Sale!

Bharatha Swathanthra Poratam
₹600.00Original price was: ₹600.00.₹510.00Current price is: ₹510.00.Add to cart - Sale!

Manorama Year Book 2025
₹350.00Original price was: ₹350.00.₹300.00Current price is: ₹300.00.Add to cart - Sale!

Telangan Samajika-Saamskruthika Charithra
₹499.00Original price was: ₹499.00.₹375.00Current price is: ₹375.00.Add to cart - Sale!

Iscon Bhagavadgita
₹500.00Original price was: ₹500.00.₹299.00Current price is: ₹299.00.Add to cart - Sale!

Vedik Maths
₹325.00Original price was: ₹325.00.₹288.00Current price is: ₹288.00.Select options This product has multiple variants. The options may be chosen on the product page - Sale!

Telangana Charithra Samskruthi-udyamalu
₹590.00Original price was: ₹590.00.₹470.00Current price is: ₹470.00.Add to cart - Sale!

Quantitative Aptitude T/M
₹699.00Original price was: ₹699.00.₹525.00Current price is: ₹525.00.Add to cart - Sale!

Quantitative Aptitude E/M
₹799.00Original price was: ₹799.00.₹599.00Current price is: ₹599.00.Add to cart - Sale!

Objective Arithmetic
₹650.00Original price was: ₹650.00.₹490.00Current price is: ₹490.00.Add to cart - Sale!

A Modern Approach to Verbal & Non verbal reasoning TM
₹725.00Original price was: ₹725.00.₹545.00Current price is: ₹545.00.Add to cart - Sale!

A Modern Approach to Verbal & Non verbal reasoning EM
₹899.00Original price was: ₹899.00.₹675.00Current price is: ₹675.00.Add to cart - Sale!

Objective General English
₹655.00Original price was: ₹655.00.₹490.00Current price is: ₹490.00.Add to cart - Sale!

A Modern Approach to Verbal Reasoning
₹649.00Original price was: ₹649.00.₹540.00Current price is: ₹540.00.Add to cart - Sale!

A Modern Approach to Logical Reasoning
₹290.00Original price was: ₹290.00.₹250.00Current price is: ₹250.00.Add to cart - Sale!

Indian History
₹749.00Original price was: ₹749.00.₹550.00Current price is: ₹550.00.Add to cart - Sale!

Arithmetic
₹499.00Original price was: ₹499.00.₹350.00Current price is: ₹350.00.Add to cart - Sale!

Reasoning
₹499.00Original price was: ₹499.00.₹350.00Current price is: ₹350.00.Add to cart - Sale!

Social and Cultural History of Andhra Pradesh
₹699.00Original price was: ₹699.00.₹550.00Current price is: ₹550.00.Add to cart - Sale!

Rajashekar Sir’s Arithmetic Class Notes
₹799.00Original price was: ₹799.00.₹450.00Current price is: ₹450.00.Select options This product has multiple variants. The options may be chosen on the product page - Sale!

Bharat – 2025
₹340.00Original price was: ₹340.00.₹275.00Current price is: ₹275.00.Add to cart - Sale!

Indian Economy
₹699.00Original price was: ₹699.00.₹525.00Current price is: ₹525.00.Add to cart - Sale!

Courseware on Indian Economy
₹725.00Original price was: ₹725.00.₹580.00Current price is: ₹580.00.Add to cart - Sale!

English Grammar and Composition Telugu medium
₹395.00Original price was: ₹395.00.₹315.00Current price is: ₹315.00.Add to cart - Sale!

English Grammar Composition
₹580.00Original price was: ₹580.00.₹490.00Current price is: ₹490.00.Add to cart - Sale!

Key to Wren & Martin’s English Grammar & Composition
₹425.00Original price was: ₹425.00.₹360.00Current price is: ₹360.00.Add to cart - Sale!

Telangana Charithra – Samskruthi & Udyama charithra
₹749.00Original price was: ₹749.00.₹499.00Current price is: ₹499.00.Add to cart - Sale!

Andrula Charithra – Samskruthi
₹749.00Original price was: ₹749.00.₹499.00Current price is: ₹499.00.Add to cart - Sale!

Indian History E/M
₹749.00Original price was: ₹749.00.₹550.00Current price is: ₹550.00.Add to cart - Sale!

Indian History T/M
₹799.00Original price was: ₹799.00.₹599.00Current price is: ₹599.00.Add to cart - Sale!

English Grammar Book
₹349.00Original price was: ₹349.00.₹260.00Current price is: ₹260.00.Add to cart - Sale!

Prelims Magnum Science & Technology (PMF IAS)
₹120.00Original price was: ₹120.00.₹119.00Current price is: ₹119.00.Add to cart -

Indian Economy Prelims Magnum by PMF IAS
₹120.00Add to cart - Sale!

Economy MCQs 450
₹250.00Original price was: ₹250.00.₹190.00Current price is: ₹190.00.Add to cart - Sale!

Objective General Knowledge
₹450.00Original price was: ₹450.00.₹350.00Current price is: ₹350.00.Add to cart - Sale!

General English
₹540.00Original price was: ₹540.00.₹430.00Current price is: ₹430.00.Add to cart - Sale!

Telangan history Telugu
₹680.00Original price was: ₹680.00.₹479.00Current price is: ₹479.00.Add to cart - Sale!

Telangan history English
₹680.00Original price was: ₹680.00.₹580.00Current price is: ₹580.00.Add to cart - Sale!
General Science
₹325.00Original price was: ₹325.00.₹250.00Current price is: ₹250.00.Add to cart - Sale!

History and Culture of Andhra Pradesh
₹375.00Original price was: ₹375.00.₹349.00Current price is: ₹349.00.Select options This product has multiple variants. The options may be chosen on the product page - Sale!

Modern Andhra Pradesh History Telugu Medium
₹375.00Original price was: ₹375.00.₹329.00Current price is: ₹329.00.Add to cart - Sale!

Telugu Saahithya Charithra
₹720.00Original price was: ₹720.00.₹560.00Current price is: ₹560.00.Add to cart - Sale!

Andrula Charithra
₹450.00Original price was: ₹450.00.₹370.00Current price is: ₹370.00.Add to cart - Sale!

Telugu Saahitya Sameeksha Books – 1 & 2 by G. Nagaiah
₹999.00Original price was: ₹999.00.₹888.00Current price is: ₹888.00.Add to cart - Sale!

Andhra Pradesh Samagra Charithra
₹300.00Original price was: ₹300.00.₹250.00Current price is: ₹250.00.Add to cart - Sale!

SSC Maths by Pinnacle Publications 8th edition (New Pattern)
₹820.00Original price was: ₹820.00.₹490.00Current price is: ₹490.00.Select options This product has multiple variants. The options may be chosen on the product page - Sale!

SSC CGL Question Bank
₹595.00Original price was: ₹595.00.₹450.00Current price is: ₹450.00.Add to cart - Sale!

IBPS Bank Clerk S/P
₹365.00Original price was: ₹365.00.₹280.00Current price is: ₹280.00.Add to cart - Sale!

Railway Group-D Solved Papers
₹635.00Original price was: ₹635.00.₹508.00Current price is: ₹508.00.Add to cart - Sale!

IBPS Clerk Practice
₹595.00Original price was: ₹595.00.₹495.00Current price is: ₹495.00.Add to cart - Sale!

IBPS Bank P.O Practice
₹525.00Original price was: ₹525.00.₹420.00Current price is: ₹420.00.Add to cart - Sale!

SSC CHSL Solved Papers
₹685.00Original price was: ₹685.00.₹548.00Current price is: ₹548.00.Add to cart - Sale!

SSC CGL Solved Papers Tier – 1 & Tier II
₹485.00Original price was: ₹485.00.₹375.00Current price is: ₹375.00.Add to cart - Sale!

SSC General Studies
₹680.00Original price was: ₹680.00.₹510.00Current price is: ₹510.00.Add to cart - Sale!

SSC Reasoning
₹770.00Original price was: ₹770.00.₹578.00Current price is: ₹578.00.Add to cart - Sale!

Ethics, Intigrity& Aptitude
₹320.00Original price was: ₹320.00.₹250.00Current price is: ₹250.00.Add to cart - Sale!

SSC English 8th Edition by Pinnacle Publications
₹830.00Original price was: ₹830.00.₹490.00Current price is: ₹490.00.Select options This product has multiple variants. The options may be chosen on the product page - Sale!

English
₹575.00Original price was: ₹575.00.₹431.00Current price is: ₹431.00.Add to cart - Sale!

Vocabulary
₹590.00Original price was: ₹590.00.₹442.00Current price is: ₹442.00.Add to cart - Sale!

India Medieval History
₹575.00Original price was: ₹575.00.₹460.00Current price is: ₹460.00.Add to cart - Sale!

Modern India History
₹525.00Original price was: ₹525.00.₹390.00Current price is: ₹390.00.Add to cart - Sale!

NCERT Summary
₹625.00Original price was: ₹625.00.₹438.00Current price is: ₹438.00.Add to cart - Sale!

Indian History
₹1,180.00Original price was: ₹1,180.00.₹885.00Current price is: ₹885.00.Add to cart - Sale!

Ethics Integrity & Aptitude
₹480.00Original price was: ₹480.00.₹384.00Current price is: ₹384.00.Add to cart - Sale!

NCERT Science & Environment
₹295.00Original price was: ₹295.00.₹249.00Current price is: ₹249.00.Add to cart - Sale!

NCERT Indian Society
₹160.00Original price was: ₹160.00.₹128.00Current price is: ₹128.00.Add to cart - Sale!

NCERT Indian Polity
₹280.00Original price was: ₹280.00.₹224.00Current price is: ₹224.00.Add to cart - Sale!

NCERT India & World Geography
₹590.00Original price was: ₹590.00.₹472.00Current price is: ₹472.00.Add to cart - Sale!

NCERT India & World History
₹890.00Original price was: ₹890.00.₹712.00Current price is: ₹712.00.Add to cart - Sale!

Pracheena Bharatha desha charithra (R S Sharma)
₹270.00Original price was: ₹270.00.₹249.00Current price is: ₹249.00.Select options This product has multiple variants. The options may be chosen on the product page - Sale!

Atomic Habits (Telugu)
₹390.00Original price was: ₹390.00.₹350.00Current price is: ₹350.00.Add to cart - Sale!

APJ Abdul Kalam in 100 Anecdotes
₹299.00Original price was: ₹299.00.₹290.00Current price is: ₹290.00.Add to cart - Sale!

Heal Your Mind
₹499.00Original price was: ₹499.00.₹449.00Current price is: ₹449.00.Add to cart - Sale!

The Wealth Money Cannot Buy
₹499.00Original price was: ₹499.00.₹449.00Current price is: ₹449.00.Add to cart - Sale!

డబ్బు – మనస్తత్వం (The Psychology of Money)
₹299.00Original price was: ₹299.00.₹290.00Current price is: ₹290.00.Add to cart - Sale!

Word Power Made Easy
₹199.00Original price was: ₹199.00.₹159.00Current price is: ₹159.00.Add to cart - Sale!

Forest Beat Officer & Assistant Beat Officer Test Series (Telugu Medium)
₹450.00Original price was: ₹450.00.₹338.00Current price is: ₹338.00.Add to cart - Sale!

Forest Beat Officer & Assistant Beat Officer Test Series (English Medium)
₹416.00Original price was: ₹416.00.₹312.00Current price is: ₹312.00.Add to cart - Sale!

Forest Section Officer (English Medium)
₹499.00Original price was: ₹499.00.₹375.00Current price is: ₹375.00.Add to cart - Sale!

A P J Abdul Kalam Wings of Fire
₹490.00Original price was: ₹490.00.₹330.00Current price is: ₹330.00.Add to cart - Sale!

TSPSC VRO Secretarial Abilities Book (Telugu Medium)
₹399.00Original price was: ₹399.00.₹319.00Current price is: ₹319.00.Add to cart - Sale!
![Indian History by Joginaidu Sir 5th Edition [Revised & Updated] [Telugu Medium]](https://shivambooks.in/wp-content/uploads/2025/07/photo_2025-04-09_10-48-34-300x225.jpg)
Indian History by Joginaidu Sir 5th Edition [Revised & Updated] [Telugu Medium]
₹729.00Original price was: ₹729.00.₹584.00Current price is: ₹584.00.Add to cart - Sale!

India’s Ancient Past by R S Sharma
₹445.00Original price was: ₹445.00.₹378.00Current price is: ₹378.00.Add to cart - Sale!

Andhra Pradesh Charithra (Telugu)
₹799.00Original price was: ₹799.00.₹639.00Current price is: ₹639.00.Add to cart -

General Knowledge by Anjaneyulu
Read more - Sale!

Telangana High Court (Office subordinate/process servers) (Telugu)
₹490.00Original price was: ₹490.00.₹350.00Current price is: ₹350.00.Add to cart - Sale!

Telangana High Court (General Knowledge & General English)
₹640.00Original price was: ₹640.00.₹520.00Current price is: ₹520.00.Add to cart - Sale!

తెలంగాణ ఉద్యమ చరిత్ర – రాష్ట్ర ఆవిర్భావం (Raghu Depaka)
₹711.00Original price was: ₹711.00.₹533.00Current price is: ₹533.00.Add to cart -

Oxford English Mini Dictionary
Read more - Sale!

Environmental Studies – Issues (English Medium)
₹349.00Original price was: ₹349.00.₹261.00Current price is: ₹261.00.Add to cart - Sale!

పర్యావరణ అధ్యయనం – సమస్యలు సుస్థిరాభివృద్ధి
₹349.00Original price was: ₹349.00.₹261.00Current price is: ₹261.00.Add to cart - Sale!

విపత్తు నిర్వహణ
₹399.00Original price was: ₹399.00.₹299.00Current price is: ₹299.00.Add to cart - Sale!

Reasoning 3.0 by Bharat Sir
₹599.00Original price was: ₹599.00.₹479.00Current price is: ₹479.00.Add to cart - Sale!

Arithmetic 3.0 Bharat Sir
₹799.00Original price was: ₹799.00.₹639.00Current price is: ₹639.00.Add to cart - Sale!

Science & Technology – General Science (Telugu)
₹780.00Original price was: ₹780.00.₹546.00Current price is: ₹546.00.Add to cart - Sale!

తెలంగాణ చరిత్ర, ఉద్యమం & కలలు – సాహిత్యం
₹620.00Original price was: ₹620.00.₹420.00Current price is: ₹420.00.Add to cart - Sale!

సమగ్ర తెలంగాణ
₹669.00Original price was: ₹669.00.₹550.00Current price is: ₹550.00.Add to cart - Sale!

RRB NTPC 29 Previous Papers
₹306.00Original price was: ₹306.00.₹214.00Current price is: ₹214.00.Select options This product has multiple variants. The options may be chosen on the product page - Sale!

మహాప్రస్థానం
₹100.00Original price was: ₹100.00.₹95.00Current price is: ₹95.00.Add to cart - Sale!

The 5 AM Club
₹399.00Original price was: ₹399.00.₹390.00Current price is: ₹390.00.Add to cart - Sale!

భారతీయ సమాజం (సామాజిక నిర్మితి, వివాదాలు & సంక్షేమ పథకాలు)
₹599.00Original price was: ₹599.00.₹449.00Current price is: ₹449.00.Add to cart - Sale!

Think and Grow Rich by Napoleon Hill
₹225.00Original price was: ₹225.00.₹220.00Current price is: ₹220.00.Add to cart - Sale!

Chanakya’s 100 Best Sutras
₹399.00Original price was: ₹399.00.₹390.00Current price is: ₹390.00.Add to cart - Sale!

కర్మ (సద్గురు)
₹199.00Original price was: ₹199.00.₹190.00Current price is: ₹190.00.Add to cart - Sale!

అమ్మ (మక్సీమ్ గోర్కి)
₹400.00Original price was: ₹400.00.₹349.00Current price is: ₹349.00.Add to cart - Sale!

The Psychology of Money by Morgan Housel
₹399.00Original price was: ₹399.00.₹390.00Current price is: ₹390.00.Add to cart - Sale!

Discover Your Destiny by Robin Sharma
₹299.00Original price was: ₹299.00.₹290.00Current price is: ₹290.00.Add to cart - Sale!

The Power of Your Subconscious Mind by Dr. Joseph Murphy
₹199.00Original price was: ₹199.00.₹190.00Current price is: ₹190.00.Add to cart - Sale!

Amma Dairylo Konni Pageelu (Telugu)
₹220.00Original price was: ₹220.00.₹210.00Current price is: ₹210.00.Add to cart - Sale!

Magical Book on Quicker Maths
₹540.00Original price was: ₹540.00.₹375.00Current price is: ₹375.00.Select options This product has multiple variants. The options may be chosen on the product page - Sale!

Analytical Reasoning by MK Pandey
₹430.00Original price was: ₹430.00.₹300.00Current price is: ₹300.00.Add to cart - Sale!

తెలంగాణ సామాజిక ఆర్థిక ముఖచిత్రం 2025
₹331.00Original price was: ₹331.00.₹249.00Current price is: ₹249.00.Add to cart - Sale!

6 Months Current Affairs by Saeed Publications (Telugu)
₹199.00Original price was: ₹199.00.₹189.00Current price is: ₹189.00.Add to cart - Sale!

Indian Economy by Sanjiv Verma – Latest 2026 Edition | UPSC & State Psc Exams (Prelims + Mains
₹599.00Original price was: ₹599.00.₹479.00Current price is: ₹479.00.Add to cart - Sale!

తెలంగాణ చరిత్ర & సంస్కృతి
₹320.00Original price was: ₹320.00.₹240.00Current price is: ₹240.00.Select options This product has multiple variants. The options may be chosen on the product page - Sale!

Tribal India Nadeem Hasnain | 8th Revised & Updated Edition | Palaka Publication ( English Medium )
₹360.00Original price was: ₹360.00.₹280.00Current price is: ₹280.00.Select options This product has multiple variants. The options may be chosen on the product page - Sale!

“Tribal Women in Development” by Lipi Mukhopadhyay
₹185.00Original price was: ₹185.00.₹175.00Current price is: ₹175.00.Add to cart - Sale!

భారతదేశ చరిత్ర (జాతియోధ్యమం)
₹320.00Original price was: ₹320.00.₹224.00Current price is: ₹224.00.Add to cart - Sale!

“1857 నాటి విశ్రుత అమరవీరులు” పుస్తకం రచయిత ఉషా చంద్ర
₹210.00Original price was: ₹210.00.₹200.00Current price is: ₹200.00.Add to cart - Sale!

“Bharateeya Janapadha Kathalu” by Mulk Raj Anand
₹95.00Original price was: ₹95.00.₹90.00Current price is: ₹90.00.Add to cart - Sale!

The Mighty and Mystical Rivers of India – Stories, History & Legends | By Alaka Shankar | Illustrated Edition by Government of India Publications
₹350.00Original price was: ₹350.00.₹320.00Current price is: ₹320.00.Add to cart - Sale!

Bharat Naari Ratnalu – Inspiring Lives of Great Indian Women | Telugu Biography Collection | Inspiring Stories
₹140.00Original price was: ₹140.00.₹135.00Current price is: ₹135.00.Select options This product has multiple variants. The options may be chosen on the product page - Sale!

India: Early History – Unveiling the Ancient Foundations of Indian Civilization
₹90.00Original price was: ₹90.00.₹85.00Current price is: ₹85.00.Add to cart - Sale!

Vivek Current Affairs Magazine by RC Reddy Publications
₹40.00Original price was: ₹40.00.₹39.00Current price is: ₹39.00.Add to cart - Sale!

Ethics, Integrity & Aptitude (GS Paper – IV) Section A
₹580.00Original price was: ₹580.00.₹520.00Current price is: ₹520.00.Add to cart - Sale!

Reasoning Class Notes (Telugu & English Medium) by VMR Logics
₹799.00Original price was: ₹799.00.₹599.00Current price is: ₹599.00.Add to cart - Sale!

VMR’s Arithmetic Class Notes (Telugu & English Medium)
₹900.00Original price was: ₹900.00.₹675.00Current price is: ₹675.00.Add to cart - Sale!

Indian Economy by Nitin Singhania
₹850.00Original price was: ₹850.00.₹560.00Current price is: ₹560.00.Select options This product has multiple variants. The options may be chosen on the product page - Sale!

Ratan Tata : A Life
₹1,499.00Original price was: ₹1,499.00.₹1,199.00Current price is: ₹1,199.00.Add to cart - Sale!

Women Who Love too Much
₹699.00Original price was: ₹699.00.₹559.00Current price is: ₹559.00.Add to cart - Sale!

The Wit & Wisdom of Ratan Tata
₹499.00Original price was: ₹499.00.₹330.00Current price is: ₹330.00.Add to cart - Sale!

Harry Potter The Complete Collection (Set of 7 Books)
₹4,999.00Original price was: ₹4,999.00.₹3,999.00Current price is: ₹3,999.00.Add to cart - Sale!

Telangana History, Movement – State Formation and Architecture (English Medium)
₹690.00Original price was: ₹690.00.₹483.00Current price is: ₹483.00.Add to cart - Sale!

Scaling Mount UPSC (Inspiring Stories of Young IAS Officers)
₹399.00Original price was: ₹399.00.₹319.00Current price is: ₹319.00.Add to cart - Sale!

Telugu Literature (Paper – 1 & 2) Reading Material
₹500.00Original price was: ₹500.00.₹399.00Current price is: ₹399.00.Add to cart - Sale!

Indian Anthropology by Nadeem Hasnain
₹290.00Original price was: ₹290.00.₹261.00Current price is: ₹261.00.Add to cart - Sale!

Tri Methods for DSC SGT & TET Paper-I & II
₹330.00Original price was: ₹330.00.₹231.00Current price is: ₹231.00.Add to cart - Sale!

6 Months Current Affairs Shine India (Telugu)
₹199.00Original price was: ₹199.00.₹189.00Current price is: ₹189.00.Add to cart - Sale!

Vedic Mathematics Made Easy
₹275.00Original price was: ₹275.00.₹270.00Current price is: ₹270.00.Add to cart - Sale!

Student Atlas for India
₹425.00Original price was: ₹425.00.₹340.00Current price is: ₹340.00.Add to cart - Sale!

Sri Chanakya Niti
₹500.00Original price was: ₹500.00.₹350.00Current price is: ₹350.00.Add to cart - Sale!

Eat That Frog for Students
₹399.00Original price was: ₹399.00.₹359.00Current price is: ₹359.00.Add to cart - Sale!

The Story of India’s Struggle for Freedom
₹135.00Original price was: ₹135.00.₹134.00Current price is: ₹134.00.Add to cart - Sale!

భారతదేశ చరిత్ర (జాతియోధ్యమం)
₹320.00Original price was: ₹320.00.₹224.00Current price is: ₹224.00.Add to cart - Sale!

TG EdCET Previous Papers
₹204.00Original price was: ₹204.00.₹153.00Current price is: ₹153.00.Add to cart - Sale!

Telangana EAPCET Engineering Entrance
₹725.00Original price was: ₹725.00.₹544.00Current price is: ₹544.00.Add to cart - Sale!

The Psychology of Marketing
₹349.00Original price was: ₹349.00.₹299.00Current price is: ₹299.00.Add to cart - Sale!

AP DSC General Knowledge and Current Affairs (Telugu)
₹169.00Original price was: ₹169.00.₹127.00Current price is: ₹127.00.Add to cart - Sale!

AP DSC School Assistant Social Studies Methodology
₹149.00Original price was: ₹149.00.₹112.00Current price is: ₹112.00.Add to cart - Sale!

AP DSC School Assistant Telugu Content & Methodology
₹239.00Original price was: ₹239.00.₹179.00Current price is: ₹179.00.Add to cart - Sale!

భారతదేశ చరిత్ర
₹799.00Original price was: ₹799.00.₹559.00Current price is: ₹559.00.Add to cart - Sale!

Maths Concept King (Formula Book)
₹360.00Original price was: ₹360.00.₹270.00Current price is: ₹270.00.Add to cart - Sale!

Railway Maths
₹395.00Original price was: ₹395.00.₹297.00Current price is: ₹297.00.Add to cart - Sale!

Maa Heeraben and Narendra: A Moving Story
₹399.00Original price was: ₹399.00.₹319.00Current price is: ₹319.00.Add to cart - Sale!

చాణక్యుడి బోధనలు మరియు సలహాలు
₹150.00Original price was: ₹150.00.₹140.00Current price is: ₹140.00.Add to cart - Sale!

Kadha Chanakya
₹250.00Original price was: ₹250.00.₹215.00Current price is: ₹215.00.Add to cart - Sale!

TG Transco Junior Personnel Officer (JPO)
₹599.00Original price was: ₹599.00.₹419.00Current price is: ₹419.00.Add to cart - Sale!

TS Transco Junior Accounts Officer (JAO)
₹599.00Original price was: ₹599.00.₹419.00Current price is: ₹419.00.Add to cart - Sale!

Telangana State Genco/Transco and Discoms Assistant Engineers
₹599.00Original price was: ₹599.00.₹419.00Current price is: ₹419.00.Add to cart - Sale!

TS Transco / TS Genco Assistant Engineers (ECE) Telecom Top 22 Papers
₹599.00Original price was: ₹599.00.₹419.00Current price is: ₹419.00.Add to cart - Sale!

TS Transco/Genco Sub-Engineers (EEE) Top 22 Papers
₹599.00Original price was: ₹599.00.₹419.00Current price is: ₹419.00.Add to cart - Sale!

Forest Beat Officer – General Science
₹248.00Original price was: ₹248.00.₹148.00Current price is: ₹148.00.Add to cart - Sale!

General Studies and General Abilities (Book 1 & Book 2) Vijetha Competitions
₹1,199.00Original price was: ₹1,199.00.₹960.00Current price is: ₹960.00.Add to cart - Sale!

Letters From a Stoic by SENECA
₹450.00Original price was: ₹450.00.₹419.00Current price is: ₹419.00.Add to cart - Sale!

Beyond Good and Evil by Friedrich Nietzche
₹399.00Original price was: ₹399.00.₹349.00Current price is: ₹349.00.Add to cart - Sale!

The Alchemist
₹299.00Original price was: ₹299.00.₹269.00Current price is: ₹269.00.Add to cart - Sale!

Ramayana by C. Rajagopalachari
₹400.00Original price was: ₹400.00.₹319.00Current price is: ₹319.00.Add to cart - Sale!

Telangana TET Paper – II Scholl Assistant (Mathematics & Science) Book-2
₹649.00Original price was: ₹649.00.₹487.00Current price is: ₹487.00.Add to cart - Sale!

Telangana TET Paper – II School Assistant (Social Studies) Book – 1
₹549.00Original price was: ₹549.00.₹412.00Current price is: ₹412.00.Add to cart - Sale!

Telangana TET Paper – II School Assistant (Mathematics & Science) Book-1
₹549.00Original price was: ₹549.00.₹412.00Current price is: ₹412.00.Add to cart - Sale!

TG TET Paper – I & II School Assistant & SGT Book – 1
₹499.00Original price was: ₹499.00.₹379.00Current price is: ₹379.00.Add to cart - Sale!

Telangana TET Paper – II School Assistant (Social Studies) Book-2
₹499.00Original price was: ₹499.00.₹374.00Current price is: ₹374.00.Add to cart - Sale!

TG TET Paper-II School Assistant Social Studies 16 Model Papers
₹149.00Original price was: ₹149.00.₹112.00Current price is: ₹112.00.Add to cart - Sale!

Telangana TET SGT Paper-I 12 Model Papers
₹89.00Original price was: ₹89.00.₹67.00Current price is: ₹67.00.Add to cart - Sale!

Telangana TET Paper-II SA Mathematics & Science 16 Model Papers
₹159.00Original price was: ₹159.00.₹119.00Current price is: ₹119.00.Add to cart - Sale!

Telangana TET Paper-I Ganitham Parisarala Vignanam Book-2
₹449.00Original price was: ₹449.00.₹337.00Current price is: ₹337.00.Add to cart - Sale!

Telangana TET Paper-I Ganitham Parisarala Vignanam Book-1
₹549.00Original price was: ₹549.00.₹412.00Current price is: ₹412.00.Add to cart - Sale!

AP DSc School Assistant Biological Science Content
₹349.00Original price was: ₹349.00.₹262.00Current price is: ₹262.00.Add to cart - Sale!

AP DSC General Knowledge & Current Affairs 5000 bits
₹149.00Original price was: ₹149.00.₹134.00Current price is: ₹134.00.Add to cart - Sale!

AP DSC School Assistant Telugu Content & Methodology
₹499.00Original price was: ₹499.00.₹379.00Current price is: ₹379.00.Add to cart - Sale!

AP DSC SGT 5 Methods Bodhana Paddathulu
₹449.00Original price was: ₹449.00.₹337.00Current price is: ₹337.00.Add to cart - Sale!

AP DSC SGT 24 Model Papers
₹189.00Original price was: ₹189.00.₹142.00Current price is: ₹142.00.Add to cart - Sale!

AP DSC Vidhya Drupkathadalu
₹299.00Original price was: ₹299.00.₹224.00Current price is: ₹224.00.Add to cart - Sale!

AP DSC School Assistant Mathematics Content
₹449.00Original price was: ₹449.00.₹359.00Current price is: ₹359.00.Add to cart - Sale!

AP DSC School Assistant Mathematics 30 Model Papers
₹299.00Original price was: ₹299.00.₹239.00Current price is: ₹239.00.Add to cart - Sale!

AP DSC 2025 Vidhya Drupkadhalu
₹699.00Original price was: ₹699.00.₹480.00Current price is: ₹480.00.Add to cart - Sale!

AP DSC Perspectives in Education 2025 (విద్యా దృక్పధాలు)
₹319.00Original price was: ₹319.00.₹269.00Current price is: ₹269.00.Add to cart - Sale!

DSC Seconday Grade Teachers 34 Model Papers
₹229.00Original price was: ₹229.00.₹172.00Current price is: ₹172.00.Add to cart - Sale!

AP DSC School Assistant Mathematics Methodology 2025
₹159.00Original price was: ₹159.00.₹127.00Current price is: ₹127.00.Add to cart - Sale!

TG TET Paper-II School Assistant Mathematics & Science 21 Previous Papers
₹149.00Original price was: ₹149.00.₹119.00Current price is: ₹119.00.Add to cart - Sale!

TG TET Paper-II School Assistant Social Studies 21 Previous Papers
₹149.00Original price was: ₹149.00.₹119.00Current price is: ₹119.00.Add to cart - Sale!

TG TET Paper-I SGT 21 Previous Papers
₹149.00Original price was: ₹149.00.₹119.00Current price is: ₹119.00.Add to cart - Sale!

TG TET Paper-II School Assistant Mathematics & Science 22 Previous Papers (English Medium)
₹149.00Original price was: ₹149.00.₹112.00Current price is: ₹112.00.Add to cart - Sale!

TG TET Paper-I Secondary Grade Teachers 23 Previous Papers (English)
₹149.00Original price was: ₹149.00.₹112.00Current price is: ₹112.00.Add to cart - Sale!

Telangana TET Paper-II School Assistant Social Studies 21 Previous Papers
₹149.00Original price was: ₹149.00.₹120.00Current price is: ₹120.00.Read more - Sale!

Aalochinchandi, Aishwaryavantulukandi (Think And Grow Rich)
₹199.00Original price was: ₹199.00.₹190.00Current price is: ₹190.00.Add to cart - Sale!

Rich Dad Poor Dad Robert T. Kiyosaki
₹599.00Original price was: ₹599.00.₹499.00Current price is: ₹499.00.Add to cart - Sale!

TG TET – 2025 Paper – II Mathematics Content & Methodology (Free: Science Content & Methodology)
₹799.00Original price was: ₹799.00.₹549.00Current price is: ₹549.00.Add to cart - Sale!

TG TET – 2025 Paper-II Social Studies Methodology (Free Book: Social Studies Content)
₹799.00Original price was: ₹799.00.₹549.00Current price is: ₹549.00.Add to cart - Sale!

TS & AP DSC SGT Top 17 Previous Papers (English Medium)
₹249.00Original price was: ₹249.00.₹170.00Current price is: ₹170.00.Add to cart - Sale!

AP DSC School Assistant 2025 Telugu Top 42 Model Papers
₹239.00Original price was: ₹239.00.₹179.00Current price is: ₹179.00.Add to cart - Sale!

AP DSC School Assistant 2025 Social Studies 35 Model Papers (including 15 Previous Papers)
₹229.00Original price was: ₹229.00.₹169.00Current price is: ₹169.00.Add to cart - Sale!

AP DSC Secondary Grade Teachers 2025 34 Previous Papers (Telugu)
₹229.00Original price was: ₹229.00.₹169.00Current price is: ₹169.00.Add to cart - Sale!

Telangana TET Paper – I & II School Assistant & Secondary Grade Teachers 2025 (Telugu)
₹499.00Original price was: ₹499.00.₹374.00Current price is: ₹374.00.Add to cart - Sale!

PET PD DSC Special Book (Telugu) Druvan Publications
₹699.00Original price was: ₹699.00.₹594.00Current price is: ₹594.00.Add to cart - Sale!

AP DSC – SGT Secondary Grade Teachers Methodology (5 Methods) (English Medium)
₹299.00Original price was: ₹299.00.₹225.00Current price is: ₹225.00.Add to cart - Sale!

AP DSC School Assistant Social Studies Content Book-1 & Book-2 (English)
₹799.00Original price was: ₹799.00.₹599.00Current price is: ₹599.00.Add to cart - Sale!

Chandan Logics Arithmetic Class Notes Bilingual 2025
₹599.00Original price was: ₹599.00.₹410.00Current price is: ₹410.00.Add to cart - Sale!

General Knowledge 2026 by Manohar Pandey
₹65.00Original price was: ₹65.00.₹59.00Current price is: ₹59.00.Add to cart - Sale!

General knowledge 2026 by Manohar Pandey
₹335.00Original price was: ₹335.00.₹261.00Current price is: ₹261.00.Add to cart - Sale!

AI: Minds & Machines – Exploring Artificial Intelligence, Human Thought & the Future of Technology
₹105.00Original price was: ₹105.00.₹95.00Current price is: ₹95.00.Add to cart - Sale!

Lives That Inspire Book in Telugu (Spoorthi Pradhathalu Voulme-1 ) – A Collection of Motivational Stories
₹105.00Original price was: ₹105.00.₹95.00Current price is: ₹95.00.Add to cart - Sale!

Lives That Inspire – Volume 2 in Telugu (Spoorthi pradhathalu) | Motivational Stories for Students & Aspirants
₹135.00Original price was: ₹135.00.₹125.00Current price is: ₹125.00.Add to cart - Sale!

Lives That Inspire – Volume 3 in Telugu (Spoorthi Pradhathalu volume 3)| Powerful Stories to Motivate Students & Aspirants
₹145.00Original price was: ₹145.00.₹135.00Current price is: ₹135.00.Add to cart - Sale!

India: Society, Religion & Literature in Ancient & Medieval Periods | Publication Division
₹120.00Original price was: ₹120.00.₹110.00Current price is: ₹110.00.Add to cart - Sale!

India: Government & Economic Life in Ancient and Medieval Periods
₹90.00Original price was: ₹90.00.₹85.00Current price is: ₹85.00.Add to cart - Sale!

పౌరుల రాజ్యాంగం – సుభాష్ సి. కశ్యప్ | Pourulu Rajyangam (Citizens & Constitution in Telugu) by Subhash C. Kashyap
₹290.00Original price was: ₹290.00.₹270.00Current price is: ₹270.00.Add to cart - Sale!

Ancient India – Publications Division
₹190.00Original price was: ₹190.00.₹180.00Current price is: ₹180.00.Add to cart - Sale!

Great Indian Women: Inspiring Lives & Contributions – Publications Division
₹150.00Original price was: ₹150.00.₹140.00Current price is: ₹140.00.Add to cart - Sale!

Indo-Islamic Architecture in India – Monuments, Art & Culture | Publications Division
₹115.00Original price was: ₹115.00.₹100.00Current price is: ₹100.00.Add to cart - Sale!

India – Before and After the Mutiny | P.C. Roy – History of 1857 Revolt
₹140.00Original price was: ₹140.00.₹130.00Current price is: ₹130.00.Add to cart - Sale!

Looking Again at Indian Art: A Journey Through India’s Artistic Heritage – Vidya Dahejia | Publications Division
₹370.00Original price was: ₹370.00.₹340.00Current price is: ₹340.00.Add to cart - Sale!

International Climate Change Negotiations: Global Policies, Treaties & India’s Role – Keshav Chaturvedi
₹200.00Original price was: ₹200.00.₹190.00Current price is: ₹190.00.Add to cart - Sale!

Chandamama Kathalu by Machiraju Kameswara Rao – Timeless Telugu Children’s Stories
₹85.00Original price was: ₹85.00.₹80.00Current price is: ₹80.00.Add to cart - Sale!

Paakudu Raallu by Ravuru Bharadwaja – Classic Telugu Novel of Social Realities
₹510.00Original price was: ₹510.00.₹500.00Current price is: ₹500.00.Add to cart - Sale!

Sahithi Sarvaswam – Complete Literary Works of Mullapudi Venkata Ramana
₹255.00Original price was: ₹255.00.₹250.00Current price is: ₹250.00.Add to cart - Sale!

Chanakya Neeti: Timeless Wisdom for Success, Leadership & Strategy – By Radhakrishnan Pillai
₹255.00Original price was: ₹255.00.₹250.00Current price is: ₹250.00.Add to cart - Sale!

Kaagitham Padavalu – Poetic Expressions of Life by V. Mallikarjun
₹155.00Original price was: ₹155.00.₹130.00Current price is: ₹130.00.Add to cart - Sale!

90’s Love Story – A Heartfelt Telugu Novel by Prasadh Ramthota
₹185.00Original price was: ₹185.00.₹180.00Current price is: ₹180.00.Add to cart - Sale!

Vaseera Lohanadhi – A Heartfelt Telugu Novel by Vaseera (Ajju Publications)
₹155.00Original price was: ₹155.00.₹150.00Current price is: ₹150.00.Add to cart - Sale!

Bhagat Singh – A Revolutionary Life by Kandimalla Prathap Reddy (Chetana Publishing House)
₹155.00Original price was: ₹155.00.₹150.00Current price is: ₹150.00.Add to cart - Sale!

Chillara Devullu by Daasarathi Rangacharya – A Landmark Telugu Novel on Society & Faith
₹185.00Original price was: ₹185.00.₹180.00Current price is: ₹180.00.Add to cart - Sale!

📖 Kalavapudi Kathalu – A Journey Through Human Emotions
₹155.00Original price was: ₹155.00.₹150.00Current price is: ₹150.00.Add to cart - Sale!

Adhunika Bharathadesh charithra by P. Raghunatharao
₹360.00Original price was: ₹360.00.₹290.00Current price is: ₹290.00.Add to cart -

The Orient BlackSwan Atlas for Competitive Examinations
₹320.00Select options This product has multiple variants. The options may be chosen on the product page - Sale!

Dayadula Thota by Madhuranthakam Narendra – A Rayalaseema Saga of Migration & Resilience
₹280.00Original price was: ₹280.00.₹275.00Current price is: ₹275.00.Add to cart - Sale!

Indian Art & Culture by Nitin Sighania 6th Edition | McGraw Hill Publication
₹975.00Original price was: ₹975.00.₹650.00Current price is: ₹650.00.Select options This product has multiple variants. The options may be chosen on the product page - Sale!

Ala Jaragalede – A Poetic Reflection on Life & Emotions | By V. Shanthi Praboda | Ajju Publications
₹155.00Original price was: ₹155.00.₹150.00Current price is: ₹150.00.Add to cart - Sale!

Meditations by Marcus Aurelius – Penguin Classics Edition | Timeless Stoic Philosophy
₹155.00Original price was: ₹155.00.₹150.00Current price is: ₹150.00.Add to cart - Sale!

Che Guevara Jeevitham – Udyamam | Kandimalla Prathap Reddy
₹155.00Original price was: ₹155.00.₹150.00Current price is: ₹150.00.Add to cart - Sale!

Che Guevara Sankshiptha Jeevitham | A Brief Biography in Telugu
₹45.00Original price was: ₹45.00.₹40.00Current price is: ₹40.00.Add to cart - Sale!

Komuram Bheem – Tribal Freedom Fighter | Bhupal | Navachetana Publishing House
₹75.00Original price was: ₹75.00.₹70.00Current price is: ₹70.00.Add to cart - Sale!

Bommala Bala Bharatam – Illustrated Mahabharata for Children | Daasarathi Krishnamacharya & C. Narayana Reddy | Navachetana Publishing House
₹135.00Original price was: ₹135.00.₹130.00Current price is: ₹130.00.Add to cart - Sale!

Naa Istam by Ram Gopal Varma | Telugu Book on Cinema, Life & Philosophy | Anvikshiki Publications
₹275.00Original price was: ₹275.00.₹270.00Current price is: ₹270.00.Select options This product has multiple variants. The options may be chosen on the product page - Sale!

Chandamama Kathalu – Timeless Telugu Stories | Boorle Nageshwar Rao | JP Publications
₹400.00Original price was: ₹400.00.₹290.00Current price is: ₹290.00.Add to cart - Sale!

Geographical Insights (From India to the World)
₹795.00Original price was: ₹795.00.₹636.00Current price is: ₹636.00.Select options This product has multiple variants. The options may be chosen on the product page - Sale!

iRise Advance Maths (Class Notes and Practice Sets)
₹799.00Original price was: ₹799.00.₹490.00Current price is: ₹490.00.Select options This product has multiple variants. The options may be chosen on the product page - Sale!

Speedy Current Affairs August 2025
₹150.00Original price was: ₹150.00.₹120.00Current price is: ₹120.00.Select options This product has multiple variants. The options may be chosen on the product page - Sale!

Indian Polity by Vinuthna (Telugu Medium)
₹69.00Original price was: ₹69.00.₹65.00Current price is: ₹65.00.Select options This product has multiple variants. The options may be chosen on the product page - Sale!

AP Geography (Telugu) by Vinuthna
₹69.00Original price was: ₹69.00.₹65.00Current price is: ₹65.00.Select options This product has multiple variants. The options may be chosen on the product page - Sale!

Indian History (Telugu) by Vinuthna
₹69.00Original price was: ₹69.00.₹65.00Current price is: ₹65.00.Select options This product has multiple variants. The options may be chosen on the product page - Sale!

General Knowledge 2026 by Vinuthna (Telugu Medium)
₹69.00Original price was: ₹69.00.₹65.00Current price is: ₹65.00.Select options This product has multiple variants. The options may be chosen on the product page - Sale!

TG DSC-2025 English Content & Pedagogy by Yes & Yes Publications
₹399.00Original price was: ₹399.00.₹279.00Current price is: ₹279.00.Select options This product has multiple variants. The options may be chosen on the product page - Sale!

TG DSC-2025 Science Content for SGT
₹419.00Original price was: ₹419.00.₹293.00Current price is: ₹293.00.Select options This product has multiple variants. The options may be chosen on the product page - Sale!

TG DSC-2025 Social Content for SGT by Yes & Yes Publications
₹419.00Original price was: ₹419.00.₹293.00Current price is: ₹293.00.Select options This product has multiple variants. The options may be chosen on the product page - Sale!

Physical Anthropology by P. Nath 13th Edition
₹650.00Original price was: ₹650.00.₹549.00Current price is: ₹549.00.Select options This product has multiple variants. The options may be chosen on the product page - Sale!

New Horizons of Public Administration by Mohit Bhattacharya
₹575.00Original price was: ₹575.00.₹465.00Current price is: ₹465.00.Select options This product has multiple variants. The options may be chosen on the product page - Sale!

Tribal India + Indian Anthropology by Nadeem Hasnain (2 books Set)
₹650.00Original price was: ₹650.00.₹540.00Current price is: ₹540.00.Select options This product has multiple variants. The options may be chosen on the product page - Sale!

Geography (India, World and Telangana) Disaster Management (Telugu Medium)
₹799.00Original price was: ₹799.00.₹599.00Current price is: ₹599.00.Select options This product has multiple variants. The options may be chosen on the product page - Sale!

Anthropology Simplified by Vivek Bhasme
₹900.00Original price was: ₹900.00.₹680.00Current price is: ₹680.00.Select options This product has multiple variants. The options may be chosen on the product page - Sale!

B2B A4 Size Paper Bundle
₹360.00Original price was: ₹360.00.₹280.00Current price is: ₹280.00.Select options This product has multiple variants. The options may be chosen on the product page - Sale!

The Constitution of India by P M Bakshi 20th Edition
₹450.00Original price was: ₹450.00.₹310.00Current price is: ₹310.00.Select options This product has multiple variants. The options may be chosen on the product page - Sale!

Geography (India, World & Telangana) + Indian History Telugu (Set of 2 Books)
₹1,598.00Original price was: ₹1,598.00.₹958.00Current price is: ₹958.00.Select options This product has multiple variants. The options may be chosen on the product page - Sale!

Punnaga Pulu (పున్నాగ పూలు)
₹350.00Original price was: ₹350.00.₹330.00Current price is: ₹330.00.Select options This product has multiple variants. The options may be chosen on the product page - Sale!

Oka Yogi Athma Katha (ఒక యోగి ఆత్మ కథ)
₹190.00Original price was: ₹190.00.₹169.00Current price is: ₹169.00.Select options This product has multiple variants. The options may be chosen on the product page - Sale!

Sita (Warrior of Mithila)
₹399.00Original price was: ₹399.00.₹279.00Current price is: ₹279.00.Select options This product has multiple variants. The options may be chosen on the product page -

Spiritual Anatomy
Read more - Sale!

Habit of Winning Stories to Inspire, Motivate and Unleash the Winner
₹399.00Original price was: ₹399.00.₹224.00Current price is: ₹224.00.Select options This product has multiple variants. The options may be chosen on the product page - Sale!

The Parable of the Pipeline
₹250.00Original price was: ₹250.00.₹224.00Current price is: ₹224.00.Select options This product has multiple variants. The options may be chosen on the product page - Sale!

You Can Win: A Step-by-Step Tool for Top Achievers Kindle
₹450.00Original price was: ₹450.00.₹310.00Current price is: ₹310.00.Select options This product has multiple variants. The options may be chosen on the product page -

Heal Your Body
Read more - Sale!

Raw Hitman
₹499.00Original price was: ₹499.00.₹399.00Current price is: ₹399.00.Select options This product has multiple variants. The options may be chosen on the product page - Sale!

Rich Dad Poor Dad
₹499.00Original price was: ₹499.00.₹349.00Current price is: ₹349.00.Select options This product has multiple variants. The options may be chosen on the product page - Sale!

Life After Death
₹899.00Original price was: ₹899.00.₹629.00Current price is: ₹629.00.Select options This product has multiple variants. The options may be chosen on the product page - Sale!

Karma
₹299.00Original price was: ₹299.00.₹210.00Current price is: ₹210.00.Select options This product has multiple variants. The options may be chosen on the product page - Sale!

Kaizen
₹699.00Original price was: ₹699.00.₹489.00Current price is: ₹489.00.Select options This product has multiple variants. The options may be chosen on the product page - Sale!

Rituals of a Happy Soul ( సంతోషకరమైన ఆత్మ యొక్క ఆచారాలు)
₹299.00Original price was: ₹299.00.₹209.00Current price is: ₹209.00.Select options This product has multiple variants. The options may be chosen on the product page - Sale!

The Art of Being Alone
₹299.00Original price was: ₹299.00.₹225.00Current price is: ₹225.00.Select options This product has multiple variants. The options may be chosen on the product page - Sale!

Deep Work
₹399.00Original price was: ₹399.00.₹229.00Current price is: ₹229.00.Select options This product has multiple variants. The options may be chosen on the product page - Sale!

When the Body Says No
₹699.00Original price was: ₹699.00.₹489.00Current price is: ₹489.00.Select options This product has multiple variants. The options may be chosen on the product page - Sale!

The power is within you
₹399.00Original price was: ₹399.00.₹299.00Current price is: ₹299.00.Select options This product has multiple variants. The options may be chosen on the product page - Sale!

Ikigai ( ఇకిగాయ్ )
₹399.00Original price was: ₹399.00.₹279.00Current price is: ₹279.00.Select options This product has multiple variants. The options may be chosen on the product page - Sale!

Lady ( స్త్రీ )
₹317.00Original price was: ₹317.00.₹225.00Current price is: ₹225.00.Select options This product has multiple variants. The options may be chosen on the product page - Sale!

గొప్ప ఆలోచనలు సృష్టించే అద్భుతాలు
₹399.00Original price was: ₹399.00.₹279.00Current price is: ₹279.00.Select options This product has multiple variants. The options may be chosen on the product page - Sale!

katha chanakya ( కథా చాణక్య )
₹250.00Original price was: ₹250.00.₹175.00Current price is: ₹175.00.Select options This product has multiple variants. The options may be chosen on the product page - Sale!

The Psychology of Marketing (మార్కెటింగ్ యొక్క మనస్తత్వశాస్త్రం)
₹349.00Original price was: ₹349.00.₹314.00Current price is: ₹314.00.Select options This product has multiple variants. The options may be chosen on the product page - Sale!

THE 48 LAWS OF POWER (48 అధికార నియమాలు)
₹999.00Original price was: ₹999.00.₹799.00Current price is: ₹799.00.Select options This product has multiple variants. The options may be chosen on the product page - Sale!

A New Earth
₹599.00Original price was: ₹599.00.₹419.00Current price is: ₹419.00.Select options This product has multiple variants. The options may be chosen on the product page - Sale!

Amish & Bhavnaroy
₹399.00Original price was: ₹399.00.₹279.00Current price is: ₹279.00.Select options This product has multiple variants. The options may be chosen on the product page - Sale!

MEN ARE FROM MARS, WOMEN ARE FROM VENUS
₹499.00Original price was: ₹499.00.₹349.00Current price is: ₹349.00.Select options This product has multiple variants. The options may be chosen on the product page - Sale!

Becoming You
₹399.00Original price was: ₹399.00.₹279.00Current price is: ₹279.00.Select options This product has multiple variants. The options may be chosen on the product page - Sale!

21 big idea that change your life
₹299.00Original price was: ₹299.00.₹245.00Current price is: ₹245.00.Select options This product has multiple variants. The options may be chosen on the product page - Sale!

Confidence
₹599.00Original price was: ₹599.00.₹419.00Current price is: ₹419.00.Select options This product has multiple variants. The options may be chosen on the product page - Sale!

unposted letters by mahatria ra english book
₹399.00Original price was: ₹399.00.₹279.00Current price is: ₹279.00.Select options This product has multiple variants. The options may be chosen on the product page - Sale!

Manifest
₹599.00Original price was: ₹599.00.₹419.00Current price is: ₹419.00.Select options This product has multiple variants. The options may be chosen on the product page - Sale!

You Can Heal Your Life
₹499.00Original price was: ₹499.00.₹349.00Current price is: ₹349.00.Select options This product has multiple variants. The options may be chosen on the product page -

Naku Nenu Rasukunna Premalekha ( నాకు నేను రాసుకున్న ప్రేమలేఖ )
₹100.00Select options This product has multiple variants. The options may be chosen on the product page - Sale!

Kagitam Padavalu ( కాగితం పాడవలు )
₹150.00Original price was: ₹150.00.₹140.00Current price is: ₹140.00.Select options This product has multiple variants. The options may be chosen on the product page - Sale!

Kings & Their Tales
₹50.00Original price was: ₹50.00.₹45.00Current price is: ₹45.00.Select options This product has multiple variants. The options may be chosen on the product page - Sale!

Marcus Aurelius ( Meditations )
₹399.00Original price was: ₹399.00.₹280.00Current price is: ₹280.00.Select options This product has multiple variants. The options may be chosen on the product page - Sale!

History of Telangana Movements By V Prakash
₹680.00Original price was: ₹680.00.₹510.00Current price is: ₹510.00.Select options This product has multiple variants. The options may be chosen on the product page - Sale!

Telangana History & Movement in Telugu
₹680.00Original price was: ₹680.00.₹510.00Current price is: ₹510.00.Select options This product has multiple variants. The options may be chosen on the product page - Sale!

దైవమిచ్చిన బార్య
₹110.00Original price was: ₹110.00.₹99.00Current price is: ₹99.00.Select options This product has multiple variants. The options may be chosen on the product page - Sale!

వివాహం
₹110.00Original price was: ₹110.00.₹99.00Current price is: ₹99.00.Select options This product has multiple variants. The options may be chosen on the product page - Sale!

శశిరేఖ
₹180.00Original price was: ₹180.00.₹162.00Current price is: ₹162.00.Select options This product has multiple variants. The options may be chosen on the product page - Sale!

ఆరెళ్ల ప్రేమ
₹170.00Original price was: ₹170.00.₹160.00Current price is: ₹160.00.Select options This product has multiple variants. The options may be chosen on the product page - Sale!

తొలి గాయం ప్రేమ ఆరంభం ప్రేరణ నున్న
₹189.00Original price was: ₹189.00.₹175.00Current price is: ₹175.00.Select options This product has multiple variants. The options may be chosen on the product page - Sale!

కలవపూడి కథలు
₹150.00Original price was: ₹150.00.₹140.00Current price is: ₹140.00.Select options This product has multiple variants. The options may be chosen on the product page - Sale!

పాకుదురుళ్ళు అత్యునత జ్ఞానపీఠ పురస్కారం ( 2012) పొందిన నవల
₹500.00Original price was: ₹500.00.₹440.00Current price is: ₹440.00.Select options This product has multiple variants. The options may be chosen on the product page - Sale!

UPSC శిఖారాగ్రాం చేరుకుందాం
₹399.00Original price was: ₹399.00.₹279.00Current price is: ₹279.00.Select options This product has multiple variants. The options may be chosen on the product page - Sale!

కాలాతీత వ్యక్తులు
₹240.00Original price was: ₹240.00.₹215.00Current price is: ₹215.00.Select options This product has multiple variants. The options may be chosen on the product page - Sale!

In The Mood For Love
₹200.00Original price was: ₹200.00.₹190.00Current price is: ₹190.00.Select options This product has multiple variants. The options may be chosen on the product page - Sale!

అలా జరగలేదే!
₹150.00Original price was: ₹150.00.₹105.00Current price is: ₹105.00.Select options This product has multiple variants. The options may be chosen on the product page - Sale!

Itihaasam ( ఇతిహాసం )
₹200.00Original price was: ₹200.00.₹190.00Current price is: ₹190.00.Select options This product has multiple variants. The options may be chosen on the product page - Sale!

Naa Ishtam
₹275.00Original price was: ₹275.00.₹250.00Current price is: ₹250.00.Select options This product has multiple variants. The options may be chosen on the product page - Sale!

Thamboolam
₹235.00Original price was: ₹235.00.₹220.00Current price is: ₹220.00.Select options This product has multiple variants. The options may be chosen on the product page - Sale!

Purnima Kathalu
₹275.00Original price was: ₹275.00.₹250.00Current price is: ₹250.00.Select options This product has multiple variants. The options may be chosen on the product page - Sale!

Donga Tallidandrulluntaru Jagratha (దొంగ తల్లిదండ్రులుంటారు జాగ్రత్త)
₹150.00Original price was: ₹150.00.₹145.00Current price is: ₹145.00.Select options This product has multiple variants. The options may be chosen on the product page - Sale!

Ammamme Godavari ( అమ్మమ్మే గోదావరి )
₹180.00Original price was: ₹180.00.₹110.00Current price is: ₹110.00.Select options This product has multiple variants. The options may be chosen on the product page - Sale!

Muthyala Muggu ( ముత్యాల ముగ్గు )
₹175.00Original price was: ₹175.00.₹160.00Current price is: ₹160.00.Select options This product has multiple variants. The options may be chosen on the product page - Sale!

Rajanigandha ( రజనీగంధ )
₹90.00Original price was: ₹90.00.₹79.00Current price is: ₹79.00.Select options This product has multiple variants. The options may be chosen on the product page - Sale!

Karpura Vasantharayallu ( “కర్పూర వసంతరాయలు” )
₹150.00Original price was: ₹150.00.₹140.00Current price is: ₹140.00.Select options This product has multiple variants. The options may be chosen on the product page - Sale!

విశ్వంభర ( Vishwambhara )
₹90.00Original price was: ₹90.00.₹75.00Current price is: ₹75.00.Select options This product has multiple variants. The options may be chosen on the product page -

జైలు లోపల ( Jailu Lopala )
₹60.00Select options This product has multiple variants. The options may be chosen on the product page - Sale!

SagaraGhosha ( సాగరఘోష )
₹500.00Original price was: ₹500.00.₹160.00Current price is: ₹160.00.Select options This product has multiple variants. The options may be chosen on the product page - Sale!

Buchibabu Chivaraku Migiledi ( చివరకు మిగిలేది )
₹320.00Original price was: ₹320.00.₹300.00Current price is: ₹300.00.Select options This product has multiple variants. The options may be chosen on the product page - Sale!

Chillara Devullu ( చిల్లర దేవుళ్ళు )
₹180.00Original price was: ₹180.00.₹155.00Current price is: ₹155.00.Select options This product has multiple variants. The options may be chosen on the product page - Sale!

Asamarduni Jeevayatra ( అసమర్దుని జీవయాత్ర )
₹120.00Original price was: ₹120.00.₹110.00Current price is: ₹110.00.Select options This product has multiple variants. The options may be chosen on the product page - Sale!

GANAPATHI ( గణపతి )
₹160.00Original price was: ₹160.00.₹150.00Current price is: ₹150.00.Select options This product has multiple variants. The options may be chosen on the product page - Sale!

మోదుగు పూలు
₹180.00Original price was: ₹180.00.₹150.00Current price is: ₹150.00.Select options This product has multiple variants. The options may be chosen on the product page - Sale!

Antarani Vasantam ( అంటరాని వసంతం )
₹300.00Original price was: ₹300.00.₹265.00Current price is: ₹265.00.Select options This product has multiple variants. The options may be chosen on the product page - Sale!

N. G. O ( ఎన్ జి ఓ )
₹75.00Original price was: ₹75.00.₹70.00Current price is: ₹70.00.Select options This product has multiple variants. The options may be chosen on the product page - Sale!

Godan ( గోదాన్ )
₹180.00Original price was: ₹180.00.₹160.00Current price is: ₹160.00.Select options This product has multiple variants. The options may be chosen on the product page - Sale!

Dabbu Amabadunu ( డబ్బు అమబడును )
₹200.00Original price was: ₹200.00.₹190.00Current price is: ₹190.00.Select options This product has multiple variants. The options may be chosen on the product page - Sale!

Mohammad Gouse 826 K.M ( మొహమ్మద్ గౌస్ )
₹225.00Original price was: ₹225.00.₹190.00Current price is: ₹190.00.Select options This product has multiple variants. The options may be chosen on the product page - Sale!

Vyaktitwa Deepam ( వ్యక్తిత్వ దీపం )
₹165.00Original price was: ₹165.00.₹155.00Current price is: ₹155.00.Select options This product has multiple variants. The options may be chosen on the product page - Sale!

Ampashayya ( అంపశయ్య )
₹325.00Original price was: ₹325.00.₹300.00Current price is: ₹300.00.Select options This product has multiple variants. The options may be chosen on the product page - Sale!

నువ్వెల్లిపోయక ( Nuvvellipoyaka )
₹275.00Original price was: ₹275.00.₹240.00Current price is: ₹240.00.Select options This product has multiple variants. The options may be chosen on the product page - Sale!

Nenu Me Bramanandham
₹375.00Original price was: ₹375.00.₹360.00Current price is: ₹360.00.Select options This product has multiple variants. The options may be chosen on the product page - Sale!

#మీటూ-కథలు. Mee Too Stories (Telugu)
₹185.00Original price was: ₹185.00.₹155.00Current price is: ₹155.00.Select options This product has multiple variants. The options may be chosen on the product page - Sale!

90’s Love Story
₹200.00Original price was: ₹200.00.₹180.00Current price is: ₹180.00.Select options This product has multiple variants. The options may be chosen on the product page - Sale!

Dheera Sameere Ganga Teere
₹220.00Original price was: ₹220.00.₹200.00Current price is: ₹200.00.Select options This product has multiple variants. The options may be chosen on the product page - Sale!

Ramagrama Nunchi Ravanalanka Daaka ( రామగ్రామ నుండి రావణలంక దాక )
₹200.00Original price was: ₹200.00.₹190.00Current price is: ₹190.00.Select options This product has multiple variants. The options may be chosen on the product page - Sale!

Bharatha Sainikula Veera Gaadhalu (Untold stories from the Indian Army)
₹200.00Original price was: ₹200.00.₹190.00Current price is: ₹190.00.Select options This product has multiple variants. The options may be chosen on the product page - Sale!

Ontaritanapu Kathalu
₹200.00Original price was: ₹200.00.₹190.00Current price is: ₹190.00.Select options This product has multiple variants. The options may be chosen on the product page - Sale!

Season End ( సీజన్ ముగింపు )
₹200.00Original price was: ₹200.00.₹190.00Current price is: ₹190.00.Select options This product has multiple variants. The options may be chosen on the product page - Sale!

Gaajula Sanchi ( గాజుల సాంచి )
₹150.00Original price was: ₹150.00.₹140.00Current price is: ₹140.00.Select options This product has multiple variants. The options may be chosen on the product page - Sale!

General Studies Paper – 1 | UPSC CSE Prelims 2026
₹1,650.00Original price was: ₹1,650.00.₹1,320.00Current price is: ₹1,320.00.Select options This product has multiple variants. The options may be chosen on the product page - Sale!

అయోధ్య చేరిన కృష్ణ (Ayodhya Cherina Krishna)
₹249.00Original price was: ₹249.00.₹200.00Current price is: ₹200.00.Select options This product has multiple variants. The options may be chosen on the product page -

Telangana movement and state Formation
₹297.00Select options This product has multiple variants. The options may be chosen on the product page -
![Indian Economy [ TELUGU MEDIUM ]](https://shivambooks.in/wp-content/uploads/2025/10/Bharata-Arthika-Vyavastha-270x225.jpg)
Indian Economy [ TELUGU MEDIUM ]
₹447.00Select options This product has multiple variants. The options may be chosen on the product page -

GENERAL STUDIES 1 ( సాధారణ అధ్యయనాలు )
₹332.00Select options This product has multiple variants. The options may be chosen on the product page -

Telangana History-Culture
₹416.00Select options This product has multiple variants. The options may be chosen on the product page -

mangali – telangana prachina sahitya charitra ( మంగళి – తెలంగాణ ప్రాచీన సాహిత్య చరిత్ర )
₹260.00Select options This product has multiple variants. The options may be chosen on the product page -

Indian Culture and Society
₹155.00Select options This product has multiple variants. The options may be chosen on the product page -

Telangana Rastra Samskruti ( తెలంగాణ చరిత్ర సంస్కృతం )
₹374.00Select options This product has multiple variants. The options may be chosen on the product page -

ప్రపంచ భూగోళ శాస్త్రం
₹218.00Select options This product has multiple variants. The options may be chosen on the product page -

Telangana Regional Geography
₹263.00Select options This product has multiple variants. The options may be chosen on the product page -

సామాజిక నిర్మాణ వివాదాలు & విధానాలు
₹200.00Select options This product has multiple variants. The options may be chosen on the product page -

తెలంగాణ ప్రాంతీయ భూగోళ శాస్త్రం
₹244.00Select options This product has multiple variants. The options may be chosen on the product page -

తెలంగాణ చరిత్ర, సంస్కృతి
₹178.00Select options This product has multiple variants. The options may be chosen on the product page -

తెలుగు తెలుగు నిఘంటువు
₹415.00Select options This product has multiple variants. The options may be chosen on the product page -

తెలంగాణ ప్రాంతీయ భూగోళ శాస్త్రం
₹244.00Select options This product has multiple variants. The options may be chosen on the product page -

Bharatha Rajyangam ( భారత రాజ్యాంగం )
₹171.00Select options This product has multiple variants. The options may be chosen on the product page -

Social Structure, Issues and Policies
₹205.00Select options This product has multiple variants. The options may be chosen on the product page -

అభివృద్ధి సమస్యలు – పరివర్తన
₹130.00Select options This product has multiple variants. The options may be chosen on the product page -

Gurukul Mains Pedagogy Of Physical Science
₹190.00Select options This product has multiple variants. The options may be chosen on the product page -

Gurukul Mains – Social Studies
₹371.00Select options This product has multiple variants. The options may be chosen on the product page -

Gurukul Mains – English Language and Literature
₹217.00Select options This product has multiple variants. The options may be chosen on the product page -

Gurukul Mains – Biological Sciences
₹424.00Select options This product has multiple variants. The options may be chosen on the product page -

Gurukul Mains Mathematics
₹420.00Select options This product has multiple variants. The options may be chosen on the product page -

Natural Disasters And Management
₹103.00Select options This product has multiple variants. The options may be chosen on the product page -

Bharathadesham Lo Sankshema Yantrangam ( భరతదేశంలో సంక్షేమ యంత్రం )
₹79.00Select options This product has multiple variants. The options may be chosen on the product page -

Bharatadeesa Charitra – Sanskruti ( భారతదేశ చరిత్ర సంస్కృతి )
₹227.00Select options This product has multiple variants. The options may be chosen on the product page -

భారతదేశ చరిత్ర-సంస్కృతి ( Indian History & Culture (Sem-I&II)TM )
₹178.00Select options This product has multiple variants. The options may be chosen on the product page -

BA Second Year Paryavarana Adhyayanam ( పర్యావరణ అధ్యయనం )
₹350.00Select options This product has multiple variants. The options may be chosen on the product page -

Intermediate Second Year Prabhutva Palana Saastram ( ఇంటర్మీడియట్ ద్వితీయ సంవత్సరం ప్రభుత్వ పాలనా శాస్త్రం )
₹159.00Select options This product has multiple variants. The options may be chosen on the product page -

పోటీ పరీక్షల కోసం ఆర్థిక అభివృద్ధి మరియు పర్యావరణం
₹182.00Select options This product has multiple variants. The options may be chosen on the product page -
![Textbook For Intermediate First Year - [ Public Administration ]](https://shivambooks.in/wp-content/uploads/2025/10/Text-Book-For-Intermidiate-First-Year-Public-Administration-280x225.jpg)
Textbook For Intermediate First Year – [ Public Administration ]
₹134.00Select options This product has multiple variants. The options may be chosen on the product page -

Intermediate First Year Public Administration Prabhutva Palana Shastram (Telugu Medium)
₹51.00Select options This product has multiple variants. The options may be chosen on the product page -
![B.A Third Year Telangana History and Culture [ ENGLISH MEDIUM ]](https://shivambooks.in/wp-content/uploads/2025/10/BA-Third-Year-Telangana-History-Culture-300x225.jpg)
B.A Third Year Telangana History and Culture [ ENGLISH MEDIUM ]
₹136.00Select options This product has multiple variants. The options may be chosen on the product page -
![B.A Third Year Telangana History and Culture [ TELUGU MEDIUM ]](https://shivambooks.in/wp-content/uploads/2025/10/B.A-Third-Year-Telangana-Charitra-Samskruti-300x225.jpg)
B.A Third Year Telangana History and Culture [ TELUGU MEDIUM ]
₹178.00Select options This product has multiple variants. The options may be chosen on the product page -
![B.A & B.SC.Third year Sem-V Bharathadesam Pranthiya bhugolasastram [Telugu Medium]](https://shivambooks.in/wp-content/uploads/2025/10/B.A-B.S.C-Third-Year-Bharatadesa-Prantiya-Bhugola-Sastram.jpeg)
B.A & B.SC.Third year Sem-V Bharathadesam Pranthiya bhugolasastram [Telugu Medium]
₹323.00Select options This product has multiple variants. The options may be chosen on the product page -

Textbook For Intermediate First Year Geography Fundamentals Of Physical Geography
₹227.00Select options This product has multiple variants. The options may be chosen on the product page -

Intermidiate First Year Bhoogola Sastram ( ఇంటర్మీడియట్ మొదటి సంవత్సరం భూగోళ శాస్త్రం )
₹222.00Select options This product has multiple variants. The options may be chosen on the product page -

A Textbook Of Intermediate First Year -HISTORY
₹174.00Select options This product has multiple variants. The options may be chosen on the product page -

Intermediate Second Year Raajaniitisastram ( ఇంటర్మీడియట్ ద్వితీయ సంవత్సరం రాజనీతిశాస్త్రం )
₹130.00Select options This product has multiple variants. The options may be chosen on the product page -
![Text Book Of Intermediate First Year - POLITICAL SCIENCE [TELUGU MEDIUM]](https://shivambooks.in/wp-content/uploads/2025/10/Rajaniti-Sastram-271x225.jpg)
Text Book Of Intermediate First Year – POLITICAL SCIENCE [TELUGU MEDIUM]
₹95.00Select options This product has multiple variants. The options may be chosen on the product page - Sale!

Reasoning Class Notes by Chandan Logics
₹799.00Original price was: ₹799.00.₹549.00Current price is: ₹549.00.Select options This product has multiple variants. The options may be chosen on the product page - Sale!

MODERN INDIA A HISTORY TEXTBOOK FOR CLASS XII
₹195.00Original price was: ₹195.00.₹100.00Current price is: ₹100.00.Select options This product has multiple variants. The options may be chosen on the product page - Sale!

Ancient India A History Textbook For Class 11
₹195.00Original price was: ₹195.00.₹100.00Current price is: ₹100.00.Select options This product has multiple variants. The options may be chosen on the product page - Sale!

Medieval India
₹195.00Original price was: ₹195.00.₹100.00Current price is: ₹100.00.Select options This product has multiple variants. The options may be chosen on the product page - Sale!

Governance in India
₹675.00Original price was: ₹675.00.₹460.00Current price is: ₹460.00.Select options This product has multiple variants. The options may be chosen on the product page - Sale!

Aadavari Matalaku ( ఆడవారి మాటలకు )
₹200.00Original price was: ₹200.00.₹180.00Current price is: ₹180.00.Select options This product has multiple variants. The options may be chosen on the product page - Sale!

Anandamaye Sakhi ( ఆనందమయే సఖి )
₹230.00Original price was: ₹230.00.₹210.00Current price is: ₹210.00.Select options This product has multiple variants. The options may be chosen on the product page - Sale!

Letters to Love
₹200.00Original price was: ₹200.00.₹180.00Current price is: ₹180.00.Select options This product has multiple variants. The options may be chosen on the product page - Sale!

Chick Lit
₹250.00Original price was: ₹250.00.₹200.00Current price is: ₹200.00.Select options This product has multiple variants. The options may be chosen on the product page - Sale!

Chemistry ( కెమిస్ట్రీ )
₹225.00Original price was: ₹225.00.₹158.00Current price is: ₹158.00.Select options This product has multiple variants. The options may be chosen on the product page - Sale!

Rama Grama nunchi Ravana Lanka Daaka (రామ గ్రామ నుంచీ రావణ లంక దాక)
₹200.00Original price was: ₹200.00.₹195.00Current price is: ₹195.00.Select options This product has multiple variants. The options may be chosen on the product page -

APPSC/TSPSC – HINDU DHARMATHATWAM – DEVALAYA VYAVASTHA
₹165.00Select options This product has multiple variants. The options may be chosen on the product page - Sale!

Mana Telugu Jaateeyalu
₹150.00Original price was: ₹150.00.₹145.00Current price is: ₹145.00.Select options This product has multiple variants. The options may be chosen on the product page - Sale!

Kaburla Devatha ( కబుర్ల దేవత )
₹175.00Original price was: ₹175.00.₹170.00Current price is: ₹170.00.Select options This product has multiple variants. The options may be chosen on the product page - Sale!

AI Minds & Machines – Yojana Collectibles | Exploring Artificial Intelligence, Ethics & Applications
₹105.00Original price was: ₹105.00.₹95.00Current price is: ₹95.00.Select options This product has multiple variants. The options may be chosen on the product page - Sale!

Apsara Exercise Spiral Book 180 Pages Unruled
₹100.00Original price was: ₹100.00.₹95.00Current price is: ₹95.00.Select options This product has multiple variants. The options may be chosen on the product page - Sale!

Apsara Exercise Spiral Book 180 Pages Ruled
₹100.00Original price was: ₹100.00.₹95.00Current price is: ₹95.00.Select options This product has multiple variants. The options may be chosen on the product page - Sale!

Apsara Exercise Spiral Book Ruled
₹220.00Original price was: ₹220.00.₹215.00Current price is: ₹215.00.Select options This product has multiple variants. The options may be chosen on the product page - Sale!

Apsara Exercise Spiral Book 302 Pages Unruled
₹145.00Original price was: ₹145.00.₹140.00Current price is: ₹140.00.Select options This product has multiple variants. The options may be chosen on the product page - Sale!

Apsara Exercise Spiral Book 302 Pages ruled
₹145.00Original price was: ₹145.00.₹140.00Current price is: ₹140.00.Select options This product has multiple variants. The options may be chosen on the product page - Sale!

Apsara Exercise Spiral Book 302 Pages ruled
₹185.00Original price was: ₹185.00.₹180.00Current price is: ₹180.00.Select options This product has multiple variants. The options may be chosen on the product page - Sale!

Apsara Exercise Spiral Book 302 Pages ruled
₹185.00Original price was: ₹185.00.₹180.00Current price is: ₹180.00.Select options This product has multiple variants. The options may be chosen on the product page -

Premium Dairy 2026
₹715.00Select options This product has multiple variants. The options may be chosen on the product page -

Mahaveer Premium Dairy 2026 Blue Colour
₹715.00Select options This product has multiple variants. The options may be chosen on the product page - Sale!

FLAIR Stellar Metal Premium Pen
₹125.00Original price was: ₹125.00.₹120.00Current price is: ₹120.00.Select options This product has multiple variants. The options may be chosen on the product page - Sale!

Hard Bound Single Ruled
₹120.00Original price was: ₹120.00.₹90.00Current price is: ₹90.00.Select options This product has multiple variants. The options may be chosen on the product page - Sale!

Premium Hard Bound Book
₹140.00Original price was: ₹140.00.₹100.00Current price is: ₹100.00.Select options This product has multiple variants. The options may be chosen on the product page - Sale!

Premium Hard Bound Book
₹140.00Original price was: ₹140.00.₹100.00Current price is: ₹100.00.Select options This product has multiple variants. The options may be chosen on the product page - Sale!

Premium Hard Bound Book
₹140.00Original price was: ₹140.00.₹100.00Current price is: ₹100.00.Select options This product has multiple variants. The options may be chosen on the product page -

Journal Cum Dairy
₹130.00Select options This product has multiple variants. The options may be chosen on the product page -

Premium Dairy Book
₹320.00Select options This product has multiple variants. The options may be chosen on the product page -

Executive Diary with Magnetic Flap
₹875.00Select options This product has multiple variants. The options may be chosen on the product page - Sale!

INTERNATIONAL RELATIONS
₹425.00Original price was: ₹425.00.₹295.00Current price is: ₹295.00.Select options This product has multiple variants. The options may be chosen on the product page - Sale!

Course Ware on Indian History
₹799.00Original price was: ₹799.00.₹590.00Current price is: ₹590.00.Select options This product has multiple variants. The options may be chosen on the product page - Sale!

Important Acts that transformed India
₹495.00Original price was: ₹495.00.₹369.00Current price is: ₹369.00.Select options This product has multiple variants. The options may be chosen on the product page - Sale!

Public Administration, 2e
₹815.00Original price was: ₹815.00.₹586.00Current price is: ₹586.00.Select options This product has multiple variants. The options may be chosen on the product page - Sale!

Objective Indian Polity 2e
₹575.00Original price was: ₹575.00.₹408.00Current price is: ₹408.00.Select options This product has multiple variants. The options may be chosen on the product page - Sale!

Indian and World Geography, 7e
₹750.00Original price was: ₹750.00.₹525.00Current price is: ₹525.00.Select options This product has multiple variants. The options may be chosen on the product page - Sale!

Ancient and Medieval Indian History, 3e
₹735.00Original price was: ₹735.00.₹507.00Current price is: ₹507.00.Select options This product has multiple variants. The options may be chosen on the product page - Sale!

Modern Indian
₹650.00Original price was: ₹650.00.₹500.00Current price is: ₹500.00.Select options This product has multiple variants. The options may be chosen on the product page - Sale!

Challenges to Internal Security of India
₹390.00Original price was: ₹390.00.₹280.00Current price is: ₹280.00.Select options This product has multiple variants. The options may be chosen on the product page - Sale!

Geography of India
₹899.00Original price was: ₹899.00.₹620.00Current price is: ₹620.00.Select options This product has multiple variants. The options may be chosen on the product page - Sale!

Seetha Rasina Ramayanam
₹220.00Original price was: ₹220.00.₹210.00Current price is: ₹210.00.Select options This product has multiple variants. The options may be chosen on the product page - Sale!

30 Days to Better English
₹199.00Original price was: ₹199.00.₹145.00Current price is: ₹145.00.Select options This product has multiple variants. The options may be chosen on the product page -

WHY SMART PEOPLE GET HACKED ?
₹115.00Select options This product has multiple variants. The options may be chosen on the product page - Sale!

Chota Bheem and the star gazing contest
₹45.00Original price was: ₹45.00.₹44.00Current price is: ₹44.00.Select options This product has multiple variants. The options may be chosen on the product page - Sale!

CHHOTA BHEEM AND THE HEROES OF DHOLAKPUR
₹45.00Original price was: ₹45.00.₹44.00Current price is: ₹44.00.Select options This product has multiple variants. The options may be chosen on the product page - Sale!

CHHOTA BHEEM A DAY IN A FOREST
₹45.00Original price was: ₹45.00.₹44.00Current price is: ₹44.00.Select options This product has multiple variants. The options may be chosen on the product page - Sale!

CHHOTA BHEEM AND THE COLOUR FUL ITCH
₹45.00Original price was: ₹45.00.₹44.00Current price is: ₹44.00.Select options This product has multiple variants. The options may be chosen on the product page - Sale!

CHHOTA BHEEM AND THE SECRET CONTEST
₹45.00Original price was: ₹45.00.₹44.00Current price is: ₹44.00.Select options This product has multiple variants. The options may be chosen on the product page - Sale!

CHHOTA BHEEM BECOMES THE KING
₹45.00Original price was: ₹45.00.₹44.00Current price is: ₹44.00.Select options This product has multiple variants. The options may be chosen on the product page - Sale!

CHHOTA BHEEM AND THE BIG CONTEST
₹45.00Original price was: ₹45.00.₹44.00Current price is: ₹44.00.Select options This product has multiple variants. The options may be chosen on the product page - Sale!

CHHOTA BHEEM AND THE GOLDEN TOUCH
₹45.00Original price was: ₹45.00.₹44.00Current price is: ₹44.00.Select options This product has multiple variants. The options may be chosen on the product page - Sale!

CHHOTA BHEEM TO THE RESCUE
₹45.00Original price was: ₹45.00.₹44.00Current price is: ₹44.00.Select options This product has multiple variants. The options may be chosen on the product page - Sale!

Nee Chupu Cheppindi naaku ( నీ చూపు చెప్పింది నాకు)
₹170.00Original price was: ₹170.00.₹160.00Current price is: ₹160.00.Select options This product has multiple variants. The options may be chosen on the product page - Sale!

Ayn Rand Philosophy అయిన్ రాండ్ ఫిలాసఫీ
₹250.00Original price was: ₹250.00.₹245.00Current price is: ₹245.00.Select options This product has multiple variants. The options may be chosen on the product page - Sale!

నా భారతదేశం: భవితకు సూచనలు
₹150.00Original price was: ₹150.00.₹145.00Current price is: ₹145.00.Select options This product has multiple variants. The options may be chosen on the product page - Sale!

Nee Kosam Nuvvu (నీ కోసం నువ్వు…)
₹150.00Original price was: ₹150.00.₹140.00Current price is: ₹140.00.Select options This product has multiple variants. The options may be chosen on the product page - Sale!

We The Living (Telugu) (వుయ్ ద లివింగ్)
₹500.00Original price was: ₹500.00.₹490.00Current price is: ₹490.00.Select options This product has multiple variants. The options may be chosen on the product page - Sale!

Fountainhead (Telugu) (ఫౌంటెన్ హెడ్)
₹750.00Original price was: ₹750.00.₹740.00Current price is: ₹740.00.Select options This product has multiple variants. The options may be chosen on the product page - Sale!

Karma – Janma
₹100.00Original price was: ₹100.00.₹90.00Current price is: ₹90.00.Select options This product has multiple variants. The options may be chosen on the product page - Sale!

Pillala Perala Pusthakam
₹120.00Original price was: ₹120.00.₹110.00Current price is: ₹110.00.Select options This product has multiple variants. The options may be chosen on the product page - Sale!

Andamaina Jeevitham అందమైన జీవితం
₹240.00Original price was: ₹240.00.₹230.00Current price is: ₹230.00.Select options This product has multiple variants. The options may be chosen on the product page - Sale!

Prema ( ప్రేమ)
₹320.00Original price was: ₹320.00.₹310.00Current price is: ₹310.00.Select options This product has multiple variants. The options may be chosen on the product page - Sale!

Anthem (Telugu) (ఏంథమ్)
₹120.00Original price was: ₹120.00.₹110.00Current price is: ₹110.00.Select options This product has multiple variants. The options may be chosen on the product page - Sale!

Manaki O Krishnudu Dhorakali
₹249.00Original price was: ₹249.00.₹240.00Current price is: ₹240.00.Select options This product has multiple variants. The options may be chosen on the product page - Sale!

నాన్న గుర్తింపు లేని సైనికుడు
₹249.00Original price was: ₹249.00.₹200.00Current price is: ₹200.00.Select options This product has multiple variants. The options may be chosen on the product page - Sale!

Seetha Rasina Ramayanam
₹220.00Original price was: ₹220.00.₹210.00Current price is: ₹210.00.Select options This product has multiple variants. The options may be chosen on the product page - Sale!

Top 42 Model Papers for Judicial Ministerial & Subordinate Service for High Court for the State of Telangana EM
₹129.00Original price was: ₹129.00.₹104.00Current price is: ₹104.00.Select options This product has multiple variants. The options may be chosen on the product page